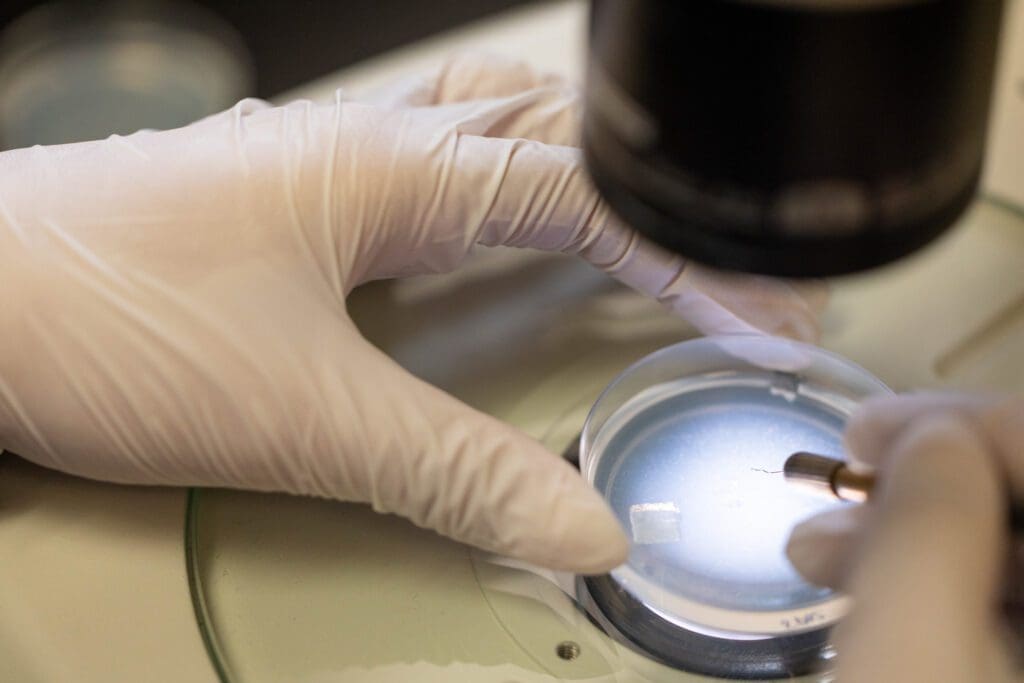

A specialized education at USC Leonard Davis introduces you to many facets of aging, providing a holistic perspective on patients’ needs. That background gives you a competitive edge in the next phase of your career. At the USC Leonard Davis School, you can earn an undergraduate gerontology degree, an accelerated five-year undergraduate/graduate degree program, a doctoral degree, or a minor in aging. All of our master’s programs are also offered in a convenient online format.

Undergraduate Programs
Our interdisciplinary curriculum focuses on biological and social development across the lifespan. Students have two options: the Social Science track or the Health Science track. Students can also pursue a minor or progressive degree.
Bachelor of Science in Human Development and Aging
Students in this program often pursue careers related to older adults in business, law, the nonprofit sector or government agencies. Students may also specialize in a health science track. The health science track combines the core gerontology curriculum with the prerequisites for admission to medical school and other health-related fields including: dentistry, pharmacy, occupational/physical therapy, physician assistant programs and others.
Bachelor of Science in Lifespan Health
The Bachelor of Science in Lifespan Health prepares students for admission to a graduate or professional school with an emphasis on the biomedical aspects of health including disease prevention, detection and treatment. This program is designed for students wishing to pursue graduate studies in a health field such as medicine, pharmacy, occupational/physical therapy, psychology and other related fields.
Minor in Gerontology: Individuals, Societies, and Aging
Rooted largely in behavioral and social science, the Minor in Individuals, Societies, and Aging is geared to students working toward careers in business, engineering, communication, arts and sciences, or cinema/television.
Minor in Gerontology: Science, Health and Aging
The Minor in Science, Health, and Aging is designed for students who want careers in medicine, dentistry, pharmacy, biological sciences, public health, or other health-related fields. This program focuses on the neurology, physiology, and health issues of aging.
Minor in Geroscience
The Minor in Geroscience provides students with the opportunity to supplement their education with a life course perspective of aging processes. The minor includes a specific focus on active participation in research and course work that emphasizes current research discoveries in geroscience.
Progressive Degree
Undergraduates with a GPA of at least 3.0 have the opportunity to complete both their undergraduate and graduate degrees in five years. They apply for admission to this program in their junior year.
Transfers
Whether you just decided to become a gerontology major or you just decided to become a Trojan, we want to hear from you! Gerontology is a vibrant, interdisciplinary field, and we take pride in finding ways for our students to make the most of their unique experiences and backgrounds.

Master’s Programs
USC Leonard Davis offers a wide range of master’s degree programs to achieve your goals. We’ll help you find the right fit, whether you’re starting your career or you’re an accomplished professional. In addition to on-campus programs, we offer online options for our gerontology master’s programs.
Master of Arts in Aging Services Management (MAASM)
The Master of Arts in Aging Services Management prepares business leaders to succeed in meeting the aging population’s unique needs, including supportive housing.
Master of Science in Applied Technology and Aging (MSATA)
The Master of Science in Applied Technology in Aging provides graduates with the knowledge and skills to support older adults’ health, independence, and safety.
Master of Science in Gerontology (MSG)
The Master of Science in Gerontology positions you at the forefront of policy and research. You’ll build your analytical skills while studying the mechanics and mysteries of longevity, aging and population health.
Master of Arts in Gerontology (MAG)
One of our field’s highest goals is ensuring that every older adult receives the care and dignity they deserve. With a Master of Arts in Gerontology, you’ll build on your career experience to champion the seniors behind the statistics.
Master of Arts in Long-Term Care Administration (MALTCA)
A Master of Arts in Long-Term Care Administration degree prepares you for leadership roles to meet this growing demand.
Master of Arts in Medical Gerontology (MAMG)
As the world’s population skews older, health care providers in all disciplines need exposure to issues of aging. The Master of Arts in Medical Gerontology prepares you for a rewarding career in meeting the health needs of older people.
Master of Arts in Senior Living Hospitality (MASLH)
Our innovative Master of Arts in Senior Living Hospitality program is designed for current and future senior living industry executives. Its emphasis on hospitality and managing residential facilities sets it apart from other gerontology degree programs.
Master of Science in Aging Biology (MSAB)
The Master of Science in Aging Biology at USC prepares the next generation of scientists to advance research in the cellular, molecular, and genetic mechanisms of aging, while also applying big data analytics to develop better treatments and prevention strategies for age-related diseases.
Master of Arts in Foodservice Management and Dietetics (MAFMD)
The Master of Arts in Foodservice Management and Dietetics will prepare students to communicate principles and practices of lifespan nutrition related to health and longevity as well as evaluate principles and practices related to wellness.
Master of Science in Nutrition, Healthspan and Longevity (MSNHL)
The Master of Science in Nutrition, Healthspan and Longevity is a degree designed for those who want to pursue a career in nutrition and dietetics.
Master of Science in Lifespan, Nutrition and Dietetics (MSLND)
The Master of Science in Lifespan, Nutrition and Dietetics program’s mission is to improve the lives of individuals by addressing the global need for professionals trained to provide nutrition and dietetics advice, information and recommendations.
Master of Science in Nutritional Science (MSNS)
The Master of Science in Nutritional Science prepares graduates with advanced knowledge, skills, and intellectual maturity to become innovative leaders in healthspan and longevity.
Specialized Master’s Programs
We have joined forces with six other professional schools at USC to offer programs in which graduates will earn two master’s degrees, gaining the knowledge and skills of gerontology as well as those of an additional professional field. Students can also pursue progressive and advanced placement programs.
Certificate Programs
Graduate Certificate in Gerontology
If you have a bachelor’s or master’s degree in another field or major, our certificate program gives you a greater understanding of gerontology theory and research. A certificate in gerontology opens up opportunities to make an impact as an aging expert across a wide range of industries.
PhD Programs
Doctor of Philosophy in Gerontology (PhD)
Future leaders in aging research must bridge disciplinary boundaries, integrating methods and data from the brain to society. Our Gerontology doctoral program brings together leading experts from neuroscience, psychology, sociology/demography, and policy to provide a unique predoctoral training environment. Here, students develop deep expertise within their chosen discipline while learning the value of incorporating cross-disciplinary perspectives to understand aging better and develop approaches to improve aging outcomes and longevity.
Doctor of Philosophy in Geroscience (PhD)
The doctoral program in Geroscience is designed for students who want to become leaders in biogerontology. The focus is on molecular, cellular, and regenerative medicine as well as the integrative biology of aging.
Doctorate Programs
Doctorate of Longevity Arts and Sciences (DLAS)
The Doctorate of Longevity Arts and Sciences (DLAS) is a unique program designed for individuals who wish to immerse themselves in the science of the human lifespan in all its dimensions.
Professional Education
The University of Southern California Leonard Davis School of Gerontology continues to be out in front on the aging education frontier. Our school has developed several certificate programs for professionals who wish to respond to the increasing demand for information and strategy on aiding the aging community.
Academic Advisement
The USC Leonard Davis School of Gerontology is committed to helping students build a vibrant, supportive academic, personal and professional network. The Office of Academic Advisement and Student Services provides services and resources related to academic advising, course planning, and registration as well as helping with any additional issues that students may have.
Academics News
USC Leonard Davis Launches New Master of Science in Aging Biology

An Introduction to Aging in South Korea


